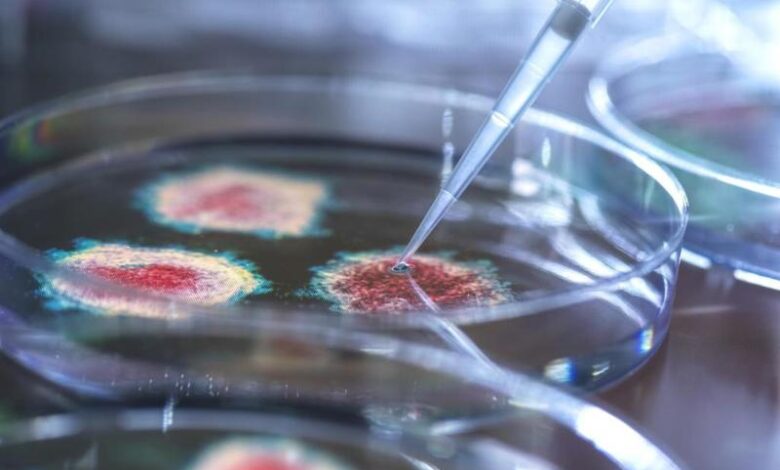

متحورات فيروس كورونا عبر العالم .. ما هي أخطر 3 متحورات
ظهرت متحورات إنكليزية وجنوب إفريقية وبرازيلية والآن هندية لفيروس كورونا حول العالم وأدت إلى طرح العديد من الأسئلة. في ما يلي ما نعرفه حتى الآن وما يعنيه هذا بالنسبة لجائحة كوفيد-19.
– كم عدد المتحورات؟
في هذه المرحلة، تعتبر ثلاث من المتحورات “مثيرة للقلق” على المستوى العالمي، وفقًا لمنظمة الصحة العالمية وهي تلك التي اكتُشفت لأول مرة في إنكلترا وجنوب إفريقيا وفي اليابان (ولكن لدى مسافرين قادمين من البرازيل، ومن هنا عرفت باسم “المتحورة البرازيلية”).
بتاريخ 27 نيسان/أبريل، كانت هذه المتحورات منتشرة على التوالي في 139 و87 و54 دولة على الأقل، وفقًا لمنظمة الصحة العالمية. وهي تنتمي إلى هذه الفئة وفق تعريف منظمة الصحة العالمية نظرًا لزيادة قابليتها للانتقال من شخص لآخر و/أو ضراوتها، ما يؤدي إلى تفاقم الوباء ويزيد من صعوبة السيطرة عليه.
قد يختلف عدد المتحورات “المثيرة للقلق” في كل بلد، اعتمادًا على الوضع المحلي. على سبيل المثال، تحصي الولايات المتحدة خمسًا منها وفقًا لتصنيف المراكز الأميركية لمكافحة الأمراض والوقاية منها وهي الثلاث المنتشرة في جميع أنحاء العالم، بالإضافة إلى اثنتين رصدتا في البداية في كاليفورنيا.
الفئة التي تليها هي فئة “المتحورات المثيرة للاهتمام”، والتي يفترض أن تخضع للمراقبة نظرًا لخصائصها الجينية التي قد تطرح إشكالية.
في الوقت الحالي، تصنف منظمة الصحة العالمية سبعًا منها على المستوى العالمي، في حين كان عددها ثلاثًا في نهاية آذار/مارس. آخر من انضم إلى هذه الفئة الثلاثاء هي المتحورة التي رُصدت في البداية في الهند. وهي تثير مخاوف بسبب التدهور السريع للوضع الصحي في هذا البلد.
اكتُشفت “المتحورات المثيرة للاهتمام” الأخرى في البدء في اسكتلندا والولايات المتحدة والبرازيل وفرنسا (في منطقة بريتاني) أو الفيليبين.
أخيرا، وبالإضافة إلى هاتين الفئتين الرئيسيتين، ينتشر العديد من المتحورات الأخرى التي يسعى المجتمع العلمي إلى رصدها وتقييمها.
يوضح إتيان سيمون لوريار رئيس وحدة الجينوميات التطورية للفيروسات التقهقرية في معهد باستور بباريس أن “الأسابيع والأشهر القادمة ستخبرنا ما إذا كانت تندرج في فئة المتحورات المثيرة للقلق الشديد والتي تنتشر بسرعة كبيرة، أم أنها ستظل متحورات تنتشر دون أن تثير الكثير من الضوضاء”.
أيا كان وضعها، تصنف كل هذه المتحورات حسب الأسرة أو “السلالة”. واعتمادًا على الطفرات التي حصلت فيها، فهي تحتل مكانًا محددًا في شجرة عائلة فيروس سارس-كوف-2 الأصلي.
– لماذا تظهر المتحورات؟
إن ظهور المتحورات ليس مفاجئًا بحد ذاته، فهذه عملية طبيعية؛ إذ يكتسب الفيروس طفرات بمرور الوقت لضمان بقائه.
وتؤكد منظمة الصحة العالمية أن “جميع الفيروسات، بما في ذلك سارس-كوف-2 تتغير بمرور الوقت، وهذا يؤدي إلى ظهور متحورات جديدة معظمها ليس له تأثير من ناحية الصحة العامة”.
كل شيء يتوقف على الطفرات التي تحملها.
ومن ثم فإن طفرة تُسمى N501Y وهي شائعة في المتحورات الإنكليزية والجنوب إفريقية والبرازيلية هي التي يُشتبه في أنها تجعل الفيروس أكثر قابلية للانتقال. وتحمل المتحورتان الجنوب إفريقية والبرازيلية طفرة أخرى تُسمى E484K يشتبه في أنها تقلل المناعة المكتسبة إما عن طريق عدوى سابقة (مع زيادة احتمال الإصابة مرة أخرى إذن)، أو عن طريق اللقاحات.
ويثير الأمر إرباكًا لدى الناس العاديين خاصة وأن هذه المتحورات تحمل أسماء متخصصة للغاية، عدا عن غياب التنسيق الدولي. فعلى سبيل المثال، تُسمى المتحورة الانكليزية 501Y.V1 أو VOC202012/01 وتنتمي إلى السلالة B.1.1.7.
ولذلك فإن مسميات المتحورات الإنكليزية أو الجنوب إفريقية أو البرازيلية أو الهندية مفهومة أكبر لغير المتخصصين، لكن العلماء لا يحبذونها، لأنهم يعتبرون أنها تترك وصمة على البلدان التي تنسب إليها.
– أشد عدوى؟
هناك إجماع على هذه النقطة فيما يتعلق “بالمتحورات الثلاث المثيرة للقلق”. لكن هذا لا يعتمد في الوقت الحالي سوى على البيانات الوبائية: يراقب الباحثون مدى سرعة انتشار هذه المتحورات ويستنتجون مدى كونها معدية.
ومن ثم لا يسمح لنا هذا بالحصول على رقم قاطع، لأن النتائج قد تختلف اعتمادًا على القيود المفروضة في المناطق المعنية.
بناءً على الدراسات المختلفة، تقدر منظمة الصحة العالمية أن المتحورة الإنكليزية أشد عدوى بنسبة 36% إلى 75%. في تقرير نُشر في نهاية شهر آذار/مارس، استشهدت المنظمة أيضًا بدراسة أجريت في البرازيل خلصت إلى أن المتحورة البرازيلية يمكن أن تكون أكثر قابلية للانتقال بمرتين ونصف المرة.
وتحوم شكوك مماثلة تحوم حول المتحورة الهندية، هذه المرة بسبب “مزيج من طفرتين معروفتين بالفعل ولكن لم يتم الربط بينهما من قبل”، وفق المجلس العلمي الذي يسدي المشورة للحكومة الفرنسية. هذه الخاصية يمكن أن تعطيها “قابلية أكبر للانتقال، ولكن ما زال يتعين إثبات ذلك على المستوى الوبائي”، وفق ما أكد المجلس في تقرير نُشر الاثنين.
يمكن أخذ عوامل أخرى في الاعتبار في التدهور الملحوظ حاليًا في الهند. وفقًا لمنظمة الصحة العالمية، يمكن تفسير ذلك جزئيًا من خلال “تجمع أعداد كبيرة من الناس أثناء المهرجانات الثقافية والدينية أو الانتخابات”، مع عدم احترام التعليمات الصحية.
تعمل عدة فرق من الباحثين حول العالم على تحليل الخصائص البيولوجية للمتحورات الرئيسية، أملًا في معرفة السبب الذي يجعلها أشد عدوى.
يقول أوليفييه شوارتز، رئيس وحدة الفيروسات والمناعة في معهد باستور ورئيس إحدى هذه الفرق لفرانس برس إن “هناك فرضيات يجب دراستها: ربما يكون الحمل الفيروسي أعلى، أو أن المتحورة يمكن أن تدخل الخلايا بسهولة أكبر أو أنها تتكاثر بسرعة أكبر”.
لكن مثل هذه الأبحاث تستغرق وقتًا، وقد لا تكون الإجابات النهائية وشيكة.
– أكثر خطورة؟
لا توجد أيضًا إجابة قاطعة عن هذا السؤال.
النسخة الإنكليزية هي التي شملتها معظم الأبحاث التي تحرت هذه النقطة. فقد خلصت دراسة نُشرت في 10 آذار/مارس إلى أنها أكثر فتكًا بنسبة 64% من فيروس كورونا الكلاسيكي، مؤكدة الملاحظات الأولية التي سجلتها السلطات البريطانية في نهاية شهر كانون الثاني/يناير.
لكن في منتصف نيسان/أبريل، أدت أعمال أخرى إلى نتائج مختلفة تظهر أن هذه المتحورة لم تتسبب بأشكال أكثر خطورة من كوفيد-19، مع أن إحدى هذه الدراسات ركزت على المرضى الذين أدخلوا إلى المستشفى. ومن ثم، فهي لا تسمح لنا بمعرفة ما إذا كانت المتحورة تتسبب بدخول عدد أكبر من المرضى إلى المستشفى من بين جميع المصابين.
– ما مدى فعالية اللقاحات؟
وفقًا للعديد من الدراسات المختبرية ونتائج الملاحظات الواقعية، لا تؤدي المتحورة الإنكليزية إلى التقليل من فعالية اللقاح بشكل كبير. من ناحية أخرى، تظهر دراسات في المختبر أن فعالية اللقاح يمكن أن تتأثر بفعل المتحورتين الجنوب إفريقية والبرازيلية، بسبب الطفرة E484K الشهيرة عليهما.
تثير المتحورة الهندية مخاوف مماثلة بسبب طفرة قريبة (E484Q)، حتى وإن كانت البيانات المتاحة حاليًا ما زالت قليلة. فقد خلصت دراسة أولية نُشرت في 23 نيسان/أبريل إلى أن لقاح كوفاكسين الذي طوره مختبر بهارات بايوتك الهندي أقل فعالية ضد هذه المتحورة منه ضد الفيروس الكلاسيكي، من حيث إنتاج الأجسام المضادة، لكنه يوفر مع ذلك حماية.
ويجدر هنا التنويه إلى أن هذا الأمر ينطبق على المتحورات الأخرى: حتى وإن كانت تجعل اللقاحات أقل فعالية، فهذا لا يعني أن التحصين لا يعود فعالاً على الإطلاق.
وما يجدر ذكره أن هذه الدراسات التي تجري في المختبر تركز على استجابة واحدة من الجسم وهي إنتاج الأجسام المضادة، ولكنها لا تقيِّم الجزء الآخر من الاستجابة المناعية التي تُسمى “المناعة الخلوية” (وتأتي من الخلايا الليمفاوية التائية والبائية).
ولكن دراسة أميركية نُشرت في 30 آذار/مارس تقدم إجابات أولية مطمئنة. وكتبت المعاهد الوطنية الأميركية للصحة على موقعها على الإنترنت أن “على الرغم من الحاجة إلى دراسات أوسع، تقترح هذه النتائج أن عمل الخلايا الليمفاوية التائية … لا يتأثر إلى حد كبير بالطفرات الموجودة في المتحورات الثلاث (الإنكليزية والجنوب إفريقية والبرازيلية) ويجب أن يوفر الحماية ضد المتحورات الناشئة”.
بغض النظر، يعمل المصنعون على إصدارات جديدة من لقاحاتهم مصممة خصيصًا للتكيف مع المتحورات.
وهذا التكيف أساسي، لأنه “يحتمل أن تستمر في الظهور متحورات يمكن أن تكون اللقاحات الحالية أقل فعالية ضدها”، كما يشير المركز الأوروبي للوقاية من الأمراض ومكافحتها.
المصدر: (مونت كارلو الدولية)







